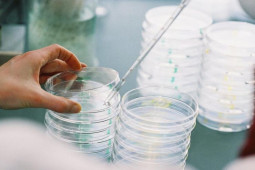
Thế giới - Điều gây lo ngại sau khi virus cổ đại gần 50.000 năm tuổi hồi sinh

Khám phá sự đáng sợ của loài rắn đã cắn chết nữ hoàng Cleopatra
Có nhiều tài liệu sử học ghi lại rằng, nữ hoàng quyền lực Cleopatra đã tự sát sau khi người tình của bà là danh tướng Antonius qua đời và cách để bà kết liễu mạng sống của mình là dùng rắn hổ mang Ai Cập cắn.
Khám phá sự đáng sợ của loài rắn đã cắn chết nữ hoàng Cleopatra
Một con chim ưng đã chọn hốc đá nhỏ hẹp để trú nắng. Tuy nhiên, con chim không thể ngờ được một con rắn hổ mang Ai...
Theo Bảo Tuấn ([Tên nguồn])
Nguồn: [Link nguồn]